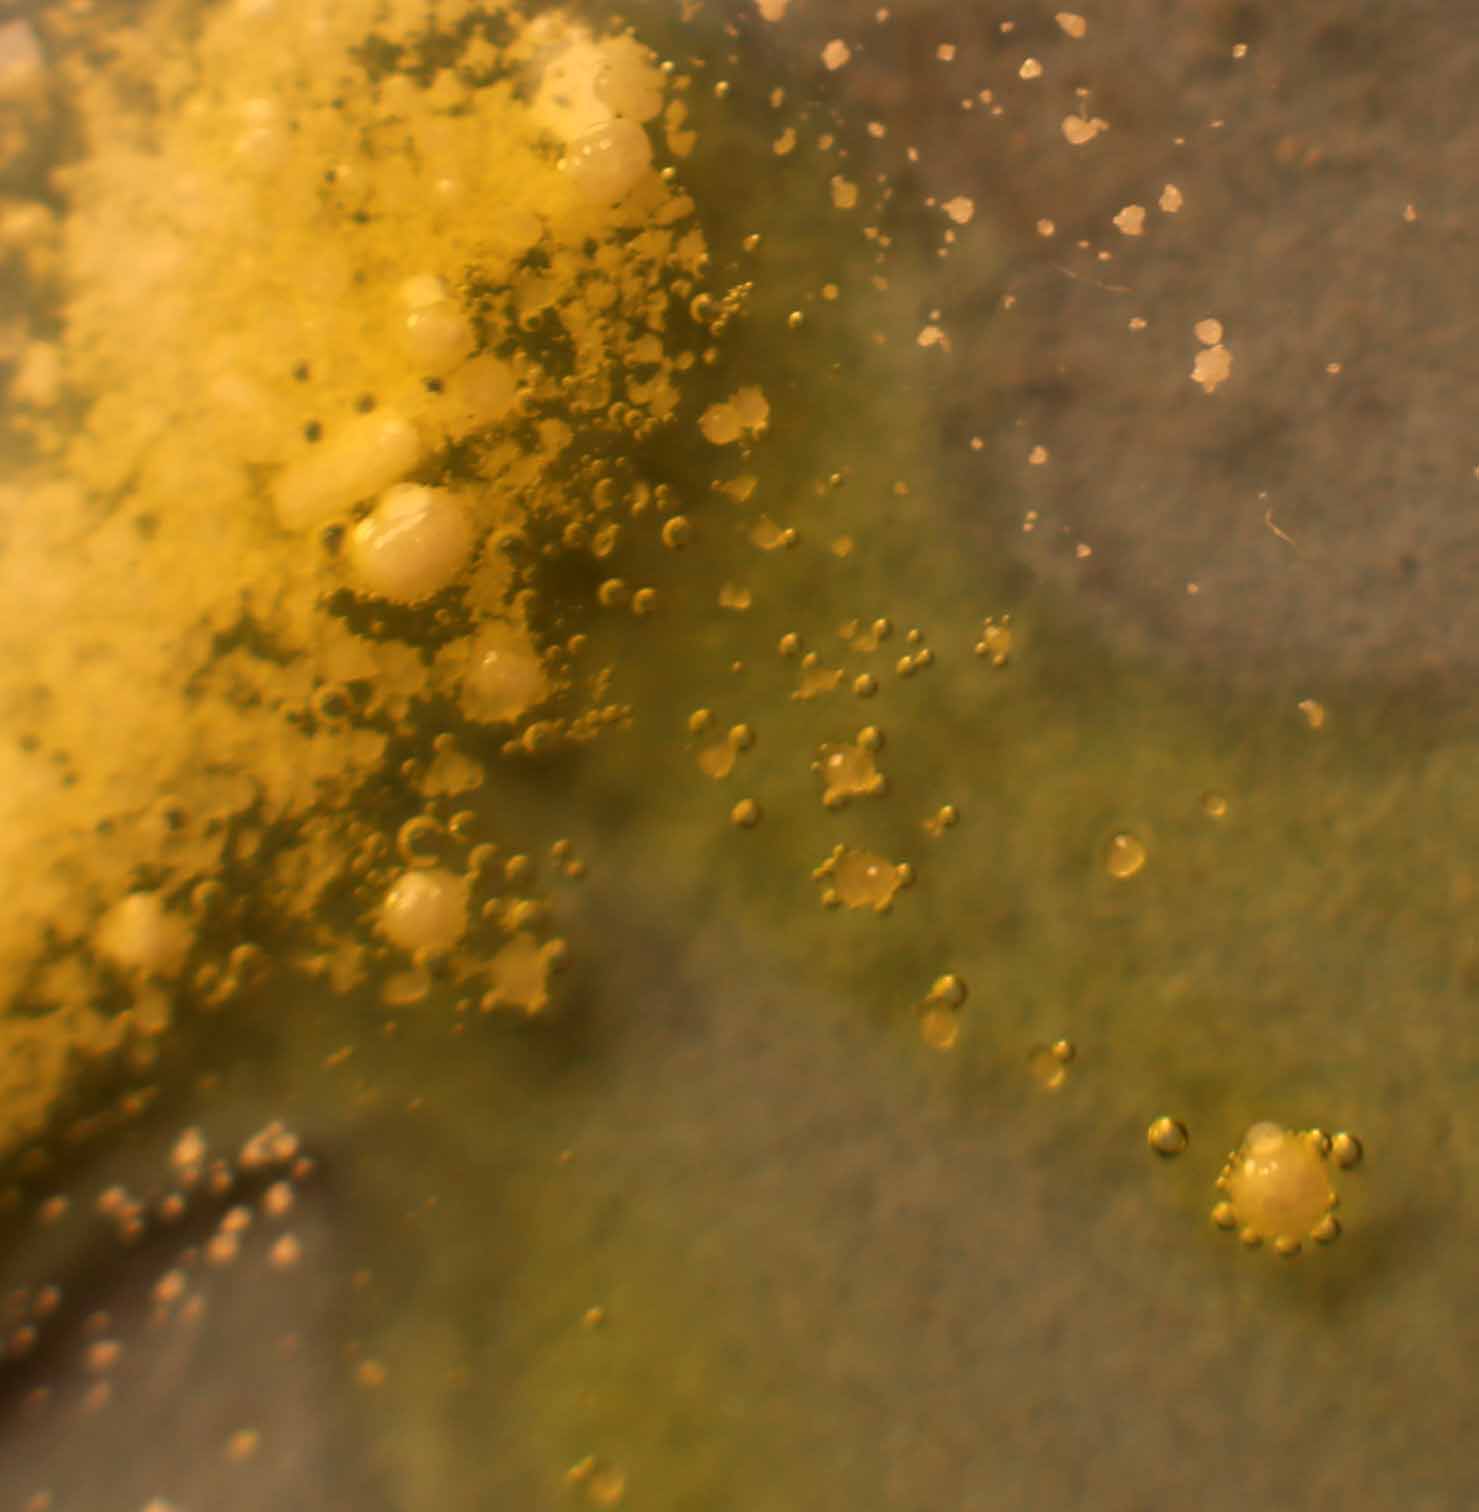

ENSEÑANZA DE LA FÍSICA Y LA QUÍMICA
PRECIPITACIÓN DE SALES DE Hg2+
6. Cloruro de mercurio(II) y yodato potásico
Partimos de una gota de cloruro de mercurio y yodato potásico (s) (fig.1).

Fig.1
Hacemos que la disolución disuelva parcialmente los cristales (fig.2)

Fig.7

Fig.6 (Detalle)

Fig.5

Fig.3
Fig.2
Al cabo de cierto tiempo se produce un precipitado blanquecino de Hg(IO3)2 (Kps=2,9.10-9), que se extiende a las dos
gotas (fig.3-7).
El proceso que tiene lugar es:
2KIO3 (s)+ HgCl2 (ac)= Hg(IO3)2(s)+2KCl(ac)
Precipitado blanco amarillento

Fig.4